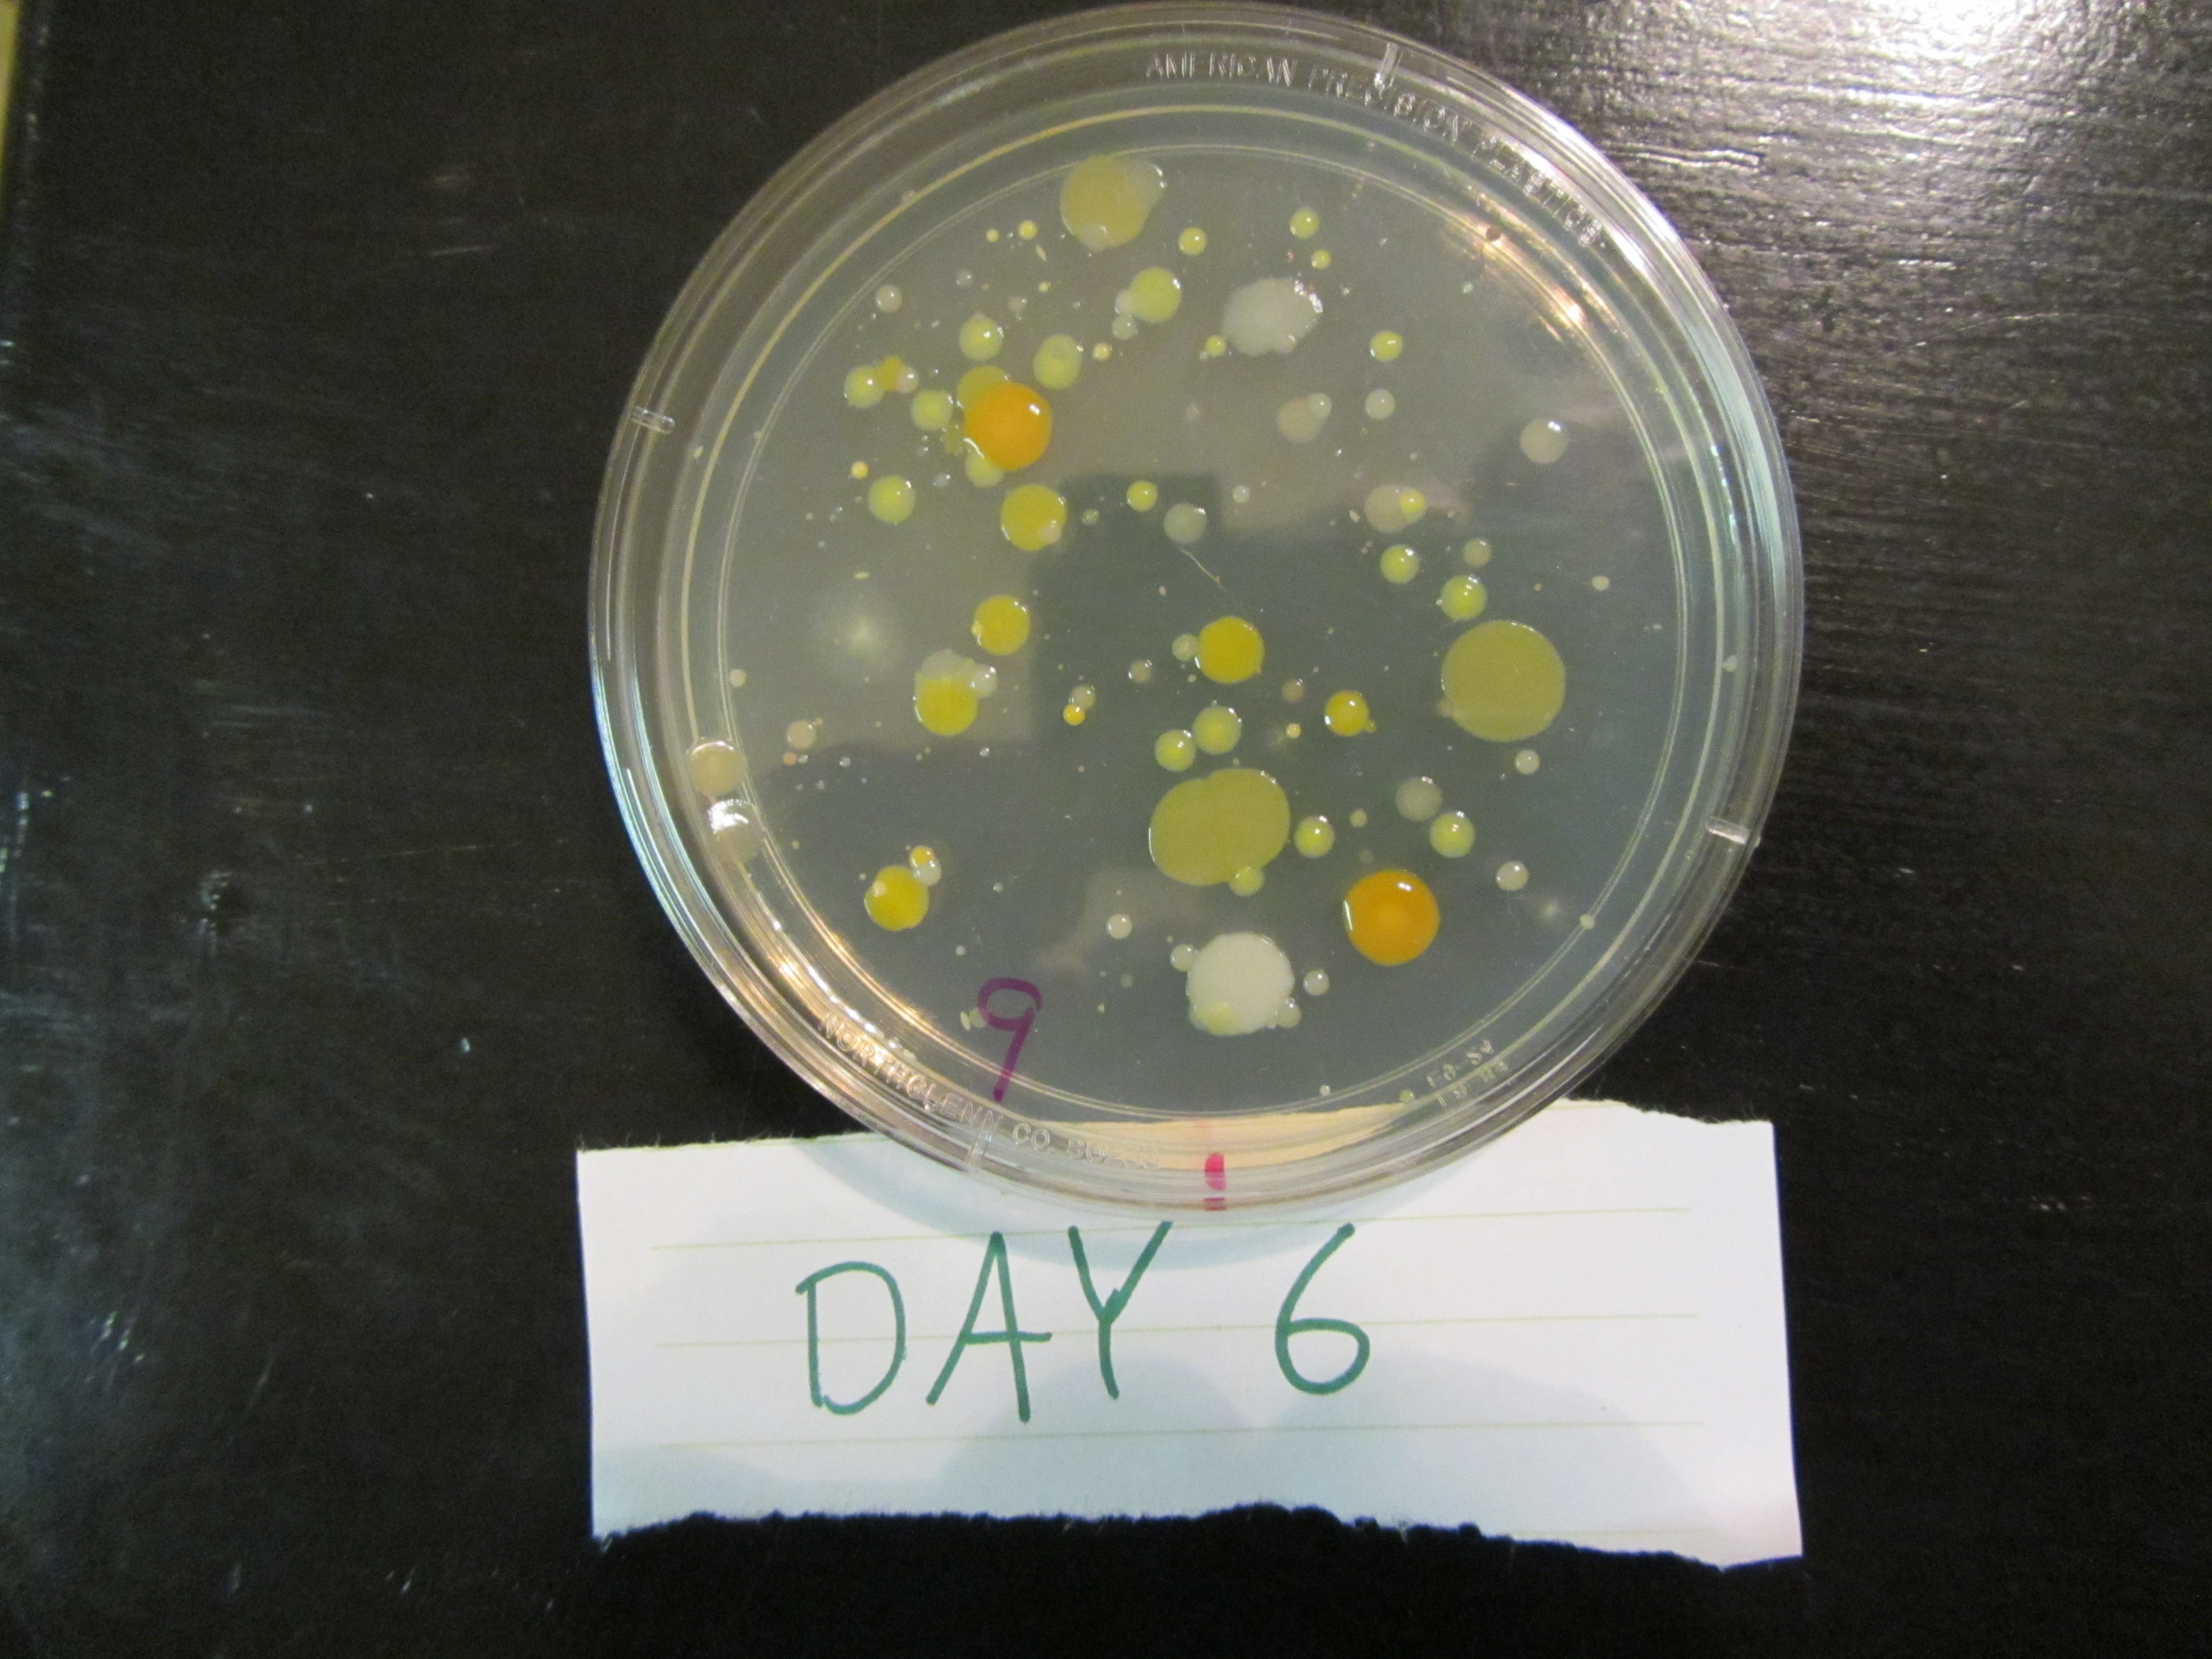

For me, one of the most attractive aspects of science is the way theories become accepted. It is a complicated process and sometimes takes years (if not decades) but the extremely difficult journey a theory takes on its way to acceptance is what makes science fun. This is counter intuitive to today’s instant results culture but it is the way science has been performed for thousands of years and it will not change.
Whether we are talking about Einstein’s General Relativity, the search for the Higgs Boson, a cure for Polio, the Heisenberg Uncertainty Principle or the effects of CO2 on Earth’s climate, the general process is always the same. A scientist proposes a theory, designs tests, gathers data, tabulates the results, draws conclusions either supporting or negating the hypothesis and publishes a paper through a peer review process.
But the process doesn’t stop there because as single test result is not enough to satisfy the highly skeptical scientific community. Those results are argued fiercely and it will take many more independent test results and published papers to further validate the theory and only then is the theory granted the lofty status of “accepted” in the general scientific community. Scientists are a skeptical lot and revel in the contentious debate of data and this is not seen as mean spirited but accepted as the norm in scientific culture.
It may seem odd to those outside that field but it is how science is carried out and this blatant willingness to open your work to intense scrutiny is what drew me to this field of study in college. What other professional field would bare to the world the intimate details of your work for the sole purpose of ridicule and proving your years of hard work incorrect? That is exactly what scientists do every day.
This past month I’ve had the joy of helping my daughter with her 5th grade science project and the results of this project reinforce the need of peer review and repetition of the test protocol to validate the results. Before I get to that, let me explain the project that we undertook.
We decided to test the bacteria and mold killing power of various hand cleaners to determine which is the best to use when washing up before a meal. Remember our moms always told us to wash our hands before eating and we wanted to see how wise our mothers were!
We decided to divide our test into 4 groups with each group containing 3 samples:
Group 1 – Control – no soap would be used
Group 2 – Dial with Triclosan (a popular ingredient in many hand soaps)
Group 3 – Softsoap (pure soap, no anti-bacterial ingredients)
Group 4 – Purell with ethyl alcohol (basically “white lightning” grain alcohol and is popular with many hand sanitizers)
We filled 12 Petri dishes with an Agar gelatin (which is great food for bacteria), divided them into the 4 groups and seeded each sample with bacteria. The bacteria came from our home PC keyboard and we used a tap water wetted cotton swab that was rubbed over the keys and then swirled over the agar in a looping back-and-forth motion. Then, for the samples in group 2, 3 and 4, we placed a drop of the soap on a cotton swab and made a vertical swipe over the agar from top to bottom and noted the plane of application with a pen mark on the Petri dish. We then covered all 12 Petri dishes, kept them in a warm environment and monitored them daily.
Our hypothesis was that hand sanitizer would be the most effective in preventing bacteria and mold growth with the Triclosan product coming in second and hand soap in third.
The results of each group after 6 days are shown in the pictures below.
Group 1 – Control
You can see bacteria and mold grew in all areas of the Petri dish and shows that using nothing to clean your hands is not a wise act because you’ll be consuming bacteria and mold when food comes in contact with your hands.
Group 2 – Dial with Triclosan
Here we see in 2 of the samples, there are no bacteria or mold growth in the center of the Petri dish where Dial with Triclosan was applied. The 2nd sample had growth in the center so the Triclosan product was only effective 67% of the time.
Group 3 – Softsoap
We see here that the plain Softsoap was effective in preventing bacteria and mold growth in 100% of the samples since there was no growth in the center of the Petri dish.
Group 4 – Purell with ethyl alcohol
These results were counter to our hypothesis in that 2 of the three ethyl alcohol samples had bacteria and mold growth in the center of the Petri dish. It should be noted that the 1st sample had growth in the center but the large blob of white growth started at the far right of the Petri dish and grew over time to cover the center so in this sample, the ethyl alcohol prevented initial growth on the application area. But still, the hand sanitizer only worked 33% of the time.
So based on our test results, you’d be better off just using normal soap instead of the Triclosan or hand sanitizer products to kill bacteria and mold. This sounds very odd so I did a search to see if there were published papers on this same topic and I found this one from the University of Kansas.
In this study, the scientists evaluated the bacteria and mold killing power of Bleach (which we didn’t test in our science project), Triclosan and hand sanitizer (ethyl alcohol). The products they used for Triclosan and hand sanitizer were equivalent to the samples we used in our science project so let’s see if there results validated the results of our science project.
It should be noted that the University of Kansas scientists used a different testing method where they combined the agar, bacteria and test soap to a solution, mixed it and then looked at growth. Here were their results.
In this paper, they found that hand sanitizer was over twice as effective as Triclosan in killing bacteria and mold growth. Bleach was the most effective but since we didn’t include Bleach in our science project I’ll leave that sample out of my discussions here.
So here we have another test that is in direct opposition to the results that we obtained with my daughter’s science project. Why the difference?
First, it is important that our testing methods were very different. The scientific paper test method didn’t take advantage of the bacteria killing mechanism of hand soap which was explained in their paper.
“The low efficiency of hand soap can also be explained by its disinfectant mechanism that it normally works by stripping away the outer layer of oil on the skin to sweep the bacteria from the surface of hands.”
Mixing the solutions together doesn’t take into account the scrubbing method used in washing your hands and our science experiment performed this scrubbing by the application of the soap on the agar with a cotton swab.
The paper also noted that there are limitations to the bacteria killing power of Ethanol (which is also known as ethyl alcohol) and this could’ve contributed to the poor performance of hand sanitizer in our science project (I have no idea why type of bacteria was present on our keyboard).
“Former researches also found that some kinds of bacteria cant’ be killed easily and have some characteristics of resistance on ethanol, some of them existing in wastewater can alive even in very high concentrations of ethanol (Yi Hsing Lin et al, 2002) (Stephen B. Pruett et, 2004), which supported this explanation. Also, some researchers found that ethanol, as a form of alcohols, is rapidly bactericidal against vegetative organisms as well as being tuberculocidal, viricidal and fungicidal but has no activity against spores (Ayliffe et al, 1993), which is also a possible reason for ethanol’s sterilizing selectivity. “
There are other issues with the way our science project was performed that could lead to inconsistent data.
We didn’t sterilize the Petri dishes prior to application and there could’ve been bacteria in the agar, dishes or swabs that introduced bacteria or mold to the results.
The swiping method of applying the soap to the Petri dish was inconsistent. Because this was my daughter’s project, I insisted that she perform the tasks. It is entirely possible that she employed varying pressures when swiping across the Agar and that could’ve scrubbed bacteria or mold off the Agar and was unrelated to the killing power of the various soaps under consideration.
We used different keys for each sample (i.e. R, S, T, L, etc.) and there could’ve been more bacteria or mold on some keys versus others.
Conclusions
Okay, so this is a lot of data and where am I going with this? The scientific process is not easy and one should be cautious in drawing dogmatic conclusions from an isolated experiment. Scientific theories do not become accepted until multiple independent experiments reach the same conclusions and we should read all research papers with a skeptical eye. This is how science has always worked and is the reason that scientists must undergo a rigorous curriculum in college that teaches analytical thinking and healthy skepticism.
From my daughter’s science project, the only thing I can say for certain is that you need to clean your keyboard periodically!












Pingback: FDA to the Rescue | cosmoscon